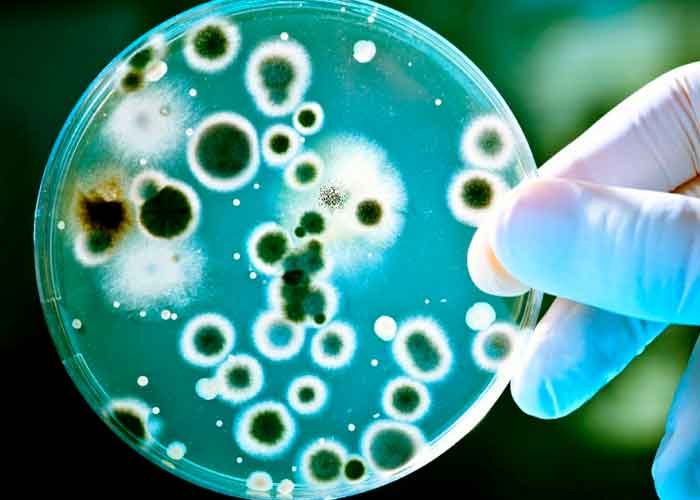

Policía Nacional informa situación de la doctora Mariam Morales Donaire
La Policía Nacional informó este miércoles, mediante una conferencia de prensa, que el caso de la doctora Mariam Elisa Morales Donaire, reportada en días...
Música
La mera luz del ritmo: ¡Se vienen Los Fabulosos...
Los Fabulosos Cadillacs, una de las agrupaciones más legendarias e influyentes del rock latinoamericano, llegan a Nicaragua este próximo...
Videos
“Barbie Girl” se queda sin banda: Aqua anuncia su separación
TM -
El grupo europeo Aqua anunció oficialmente su separación definitiva tras casi 30 años de carrera artística. La banda, reconocida mundialmente por el éxito “Barbie...